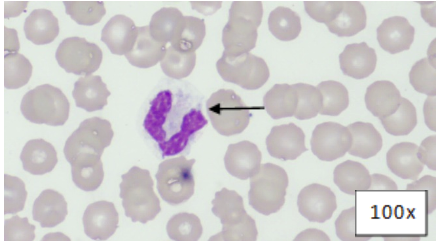
figure one

August 2023
Case Report: Salmonella enteritidis
By Ryan Davila and Daniela Hernandez Muguiro, DVM, DACVP (Clinical Pathology)
Case Presentation
A 1.5-year-old male Pudelpointer presented to the K-State Veterinary Health Center with a history of anorexia, fever, retching/vomiting multiple times a day, as well as diarrhea and straining to defecate for a few days. In the previous six months, the patient had undergone two abdominal explore/foreign body surgeries performed by the referring veterinarian. The patient had previously tested negative on a SNAP 4DX test and tick PCR panel, had received IV fluids and cerenia, and was treated with antibiotics with only slight improvement noted.
Initial Bloodwork
On Day 1 of the patient’s stay in the VHC, a complete blood count (CBC) was performed, and the abnormal values are shown in Table 1.
![]() |
Table 1. CBC, Day 1
The CBC showed a moderate to marked neutrophilia with left-shift and monocytosis, which were supportive of a severe inflammatory process.
Review of a blood smear showed neutrophils with toxic change characterized by cytoplasmic basophilia and vacuolization, and Dohle bodies further supporting inflammation (Figure 1).
![]() |
Figure 1: Blood Smear, Wright's-Giemsa. Segmented neutrophil with cytoplasmic basophilia, vacuolation, and Dohle bodies (arrow).
A serum biochemical profile was performed, and the abnormal values are shown in Table 2.
![]() |
Table 2: Serum Biochemical Data, Day 1
The hyponatremia, hypokalemia, low bicarbonate, low total protein, and hypoalbuminemia were attributed to the vomiting, diarrhea, and anorexia. A protein-losing process was considered possible. The low creatinine was attributed to low muscle mass. The high ALP and total bilirubin supported cholestasis, with the ALP likely also elevated in part due to a corticosteroid/stress effect. The hypoglycemia was concerning for sepsis. A coagulation panel was performed. The prothrombin time (PT) was within normal limits at 8.1 seconds (RI: 7-10 seconds), while the activated partial thromboplastin time (APTT) was prolonged at 19.2 seconds (RI: 10-16 seconds). The prolonged APTT and thrombocytopenia (Table 1) supported a clinical suspicion for disseminated intravascular coagulation (DIC).
Cytology
A fine-needle-aspirate (FNA) of the liver was performed due to the presumed cholestasis, and a representative image of this FNA is included (Figure 2).
![]() |
Figure 2: Liver FNA, Wright’s-Giemsa. Variably intact hepatocytes and a bile cast (arrow).
There were several bile casts observed, which confirmed cholestasis.
The patient was noted to have peritoneal effusion on his physical exam, and a sample of this fluid was collected and submitted for cytology. A representative image of this fluid cytology is included (Figure 3).
![]() |
Figure 3: Peritoneal Effusion, Wright’s-Giemsa. Numerous neutrophils and few macrophages in a background of blood.
The peritoneal fluid total protein concentration was 3.2 g/dL, and the total nucleated cell count was 91,872 cells/uL. These values indicate that this fluid is an exudate. A 100-count differential of the nucleated cells was performed, with 91% non-degenerate neutrophils, 6% mildly vacuolated macrophages, and 3% small lymphocytes observed. Although no infectious organisms were seen, the cells observed, along with the patient’s clinical signs, suggested a septic peritonitis.
Final diagnosis
Due to the concern for septic peritonitis, a bacterial culture was performed on the peritoneal fluid. The anaerobic culture was negative for bacteria, while the aerobic culture was positive for Salmonella sp. This finding, along with the other test results and clinical signs, allowed for a final diagnosis of enteritis, septic peritonitis, and septicemia secondary to Salmonella sp. infection. The patient’s in-hospital treatments included IV dextrose/fluids, heparin, fresh-frozen plasma, enrofloxacin, carprofen, cerenia, and ondansetron.
Follow-up
On Day 5 of the patient’s stay in the KSU VHC, a repeat CBC was performed to monitor the patient's response following two days of treatment. The abnormal values are shown in the table below.
![]() |
Table 4: Repeat CBC, Day 5 of hospitalization, (2 days after starting treatment).
The patient now had a less severe neutrophilia, left shift, and thrombocytopenia. A repeat coagulation profile was performed, with a PT of 7.9 seconds (RI: 7-10 seconds) and an APTT of 13.9 seconds (RI: 10-16 seconds). These CBC results and normalization of APTT supported adequate response to treatment. At this time, the patient’s lethargy, fever, and appetite had all improved, and he was discharged with enrofloxacin, carprofen, and instructions to recheck with the primary veterinarian every 2 weeks.
A sample of the peritoneal fluid was sent off for Salmonella serotyping, and results came back as Salmonella enteritidis.
Case Discussion
Salmonella spp. are gram-negative bacteria that are uncommon in the intestinal tract of healthy dogs.1 The prevalence of salmonellosis in household or shelter dogs is between 0-2.9%1, with the higher prevalence often associated with dogs being fed raw meat (Figure 4).2
Figure 4. Summary of the various sources of exposure to Salmonella spp. in dogs and cats, and factors that contribute to clinical salmonellosis.2
There are numerous Salmonella serovars that have been isolated from dogs, with both Salmonella typhimurium and Salmonella enteritidis known for having a worldwide distribution2, as well as being the serovars most frequently associated with enteritis in humans.3 Salmonella enteritidis is especially associated with exposure of dogs to raw or undercooked poultry meat or eggs.2 Exposure to Salmonella spp. results in either colonization or clinical infection.4 For cases of clinical infection, disease may be mild with only self-limited diarrhea, or disease may be severe with hemorrhagic gastroenteritis and septicemia.2 Other clinical signs associated with infection may include fever, vomiting, abdominal pain, and lethargy.2 In addition to these clinical signs, diagnosis of salmonellosis depends on detection of organisms via bacterial culture of feces or other sites, such as cavitary effusions.2 Treatment for salmonellosis depends on the severity of disease, and often requires between 3-6 months of antibiotics to eradicate the infection. In this case, the patient exhibited clinical signs that were consistent with severe salmonellosis with septicemia. Although it’s not clear what led to clinical salmonellosis in this patient, it’s thought that the prior abdominal explore surgeries could have contributed to the infection and subsequent septic peritonitis and septicemia2; the latter would explain the abnormal CBC data, hypoglycemia, and trigger for DIC. The cholestasis was likely functional due to inflammatory cytokines and bacterial endotoxins.
In conclusion, this case is an example of severe clinical salmonellosis in a dog, with clinical and laboratory findings supportive of septicemia. At the time of this write-up, the patient was reported by the primary veterinarian to be responding well to treatments at home and was back to being his normal self. His latest bloodwork revealed a white blood cell count of 12.2 K/uL (Reference Interval, RI: 4.3-13.6 K/uL) with a normal differential count, a platelet count of 436 K/uL (RI: 130-370 K/uL), and an ALP of 398 U/L (RI: 11-139 U/L), down from 1,776 U/L one month prior.
References
- Weese, J.S. Bacterial enteritis in dogs and cats: diagnosis, therapy, and zoonotic potential. Vet Clin North Am Small Anim Pract. 2011 Mar; 41(2):287-309.
- Carter, M. E. & Quinn, P. J. (2000). Salmonella in dogs and cats. In: Salmonella in Domestic Animals, Wray, C. & Wray A. (Eds), pp. 231-244, CAB International Publishing, ISBN 0851992617, Oxon, UK.
- Grunberg, W. (2023, July 19). Salmonellosis in animals - digestive system. Merck Veterinary Manual. https://www.merckvetmanual.com/digestive-system/salmonellosis/salmonellosis-in-animals
- 4. Centers for Disease Control and Prevention. (2022, July 20). Salmonella infection. Centers for Disease Control and Prevention. https://www.cdc.gov/healthypets/diseases/salmonella.html#:~:text=Pets %20and%20Salmonella,hospitalized%20in%20a%20veterinary%20clinic
Ryan Davila, DVM is a Diagnostic Medicine Intern at KSVDL
Daniela Hernandez Muguiro, DVM, DACVP (Clinical Pathology) is a Clinical Pathologist at KSVDL